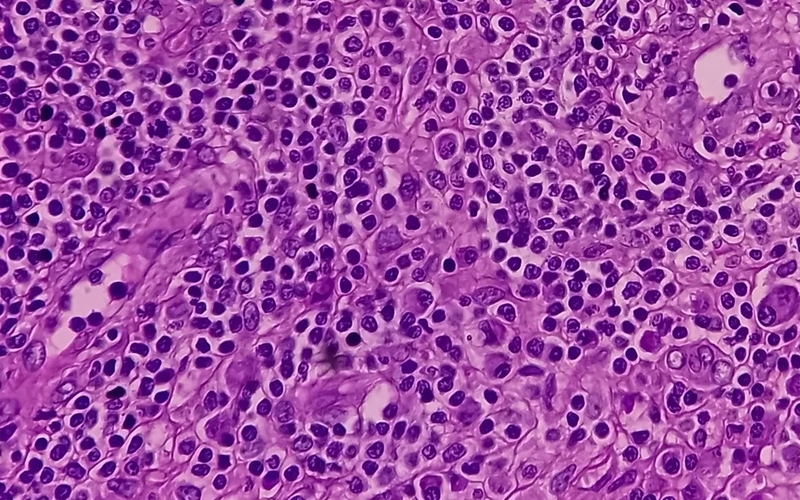
Phương pháp chẩn đoán và hướng điều trị hội chứng mô bào ở trẻ em 2

Tốt nghiệp Đại Học Dược Hà Nội - chuyên môn Dược lâm sàng. Hiện đang là giảng viên cho Dược sĩ tại Nhà thuốc Long Châu.
Ánh Vũ
01/02/2024
Mặc định
Lớn hơn
Hội chứng mô bào xảy ra khi có sự phát triển quá mức của các tế bào Langerhans gây tổn thương mô và viêm với nhiều triệu chứng ở nhiều cơ quan trong cơ thể, thường xảy ra ở trẻ nhỏ. Vậy hội chứng mô bào được chẩn đoán và điều trị như thế nào?
Hội chứng mô bào đặc trưng bởi hiện tượng chốc đầu kéo dài. Khi trẻ bị chốc đầu trong thời gian dài mà điều trị da liễu không hiệu quả thì rất có thể trẻ đã mắc hội chứng mô bào. Trước khi tìm hiểu phương pháp chẩn đoán cũng như điều trị chứng mô bào ở trẻ em, hãy cùng Nhà thuốc Long Châu điểm qua một vài nét cơ bản về hội chứng này bạn nhé.
Hội chứng mô bào hay còn gọi là bệnh mô bào Langerhans, đặc trưng bởi sự tăng sinh và tích tụ bất thường của các tế bào Langerhans - loại tế bào thuộc hệ thống bạch cầu đơn nhân đại thực bào.
Bình thường, Langerhans là tế bào thuộc hệ miễn dịch, đảm nhận vai trò bảo vệ cơ thể trước các tác nhân gây bệnh. Tuy nhiên, ở trẻ mắc hội chứng mô bào, các tế bào này lại nhân lên một cách bất thường và phát triển quá mức gây tổn thương nhiều cơ quan quan trọng trong cơ thể như hệ thống tạo máu, mô xương, phổi, hạch lympho, gan, lách…
Hội chứng mô bào là một hội chứng khá hiếm gặp và bất cứ ai cũng có nguy cơ mắc phải hội chứng này. Tuy nhiên, bệnh thường chủ yếu gặp ở đối tượng là trẻ em.
Theo thống kê, mỗi năm có khoảng 5,4 triệu trẻ em mắc căn bệnh này và tỷ lệ mắc bệnh ở trẻ nam thường cao hơn trẻ nữ.
Các chuyên gia y tế chỉ ra rằng, tiên lượng của bệnh với trẻ trên 2 tuổi khá tốt, chỉ gây tổn thương tại một trong các cơ quan như da, xương và hạch bạch huyết. Song, đối với trẻ dưới 2 tuổi thì tổn thương thường xảy ra ở nhiều cơ quan.
Tính đến thời điểm hiện tại, các nhà khoa học vẫn chưa tìm ra được nguyên nhân cụ thể gây bệnh. Tuy nhiên, một số yếu tố được đánh giá có thể làm tăng nguy cơ mắc bệnh phải được kể đến như môi trường sống ngột ngạt, trong gia đình có người mắc ung thư trước đó, phụ nữ mang thai bị nhiễm trùng trước và sau khi sinh cũng làm tăng nguy cơ trẻ sau khi sinh ra bị mắc bệnh.

Tuỳ thuộc vào vị trí, mức độ tổn thương mà các triệu chứng của hội chứng mô bào ở mỗi người là khác nhau. Khi mắc hội chứng mô bào, trẻ có thể gặp một số triệu chứng sau:
Tổn thương thường xảy ra ở các vùng da đầu, mặt, mông, các vùng nếp gấp và thân mình. Các tổn thương này có thể ở dạng tróc vảy, sần phù cứng màu nâu hoặc màu vàng, nằm tập trung hoặc lan rộng, ban xuất huyết dạng sần, có thể có rỉ nước giống như viêm da tiết bã nhờn.
Các tổn thương vùng da đầu ở trẻ mắc hội chứng mô bào rất dễ khiến cha mẹ nhầm lẫn với hiện tượng chốc đầu ở trẻ em. Điều này dẫn đến kéo dài thời gian phát hiện bệnh và khiến cho tổn thương ngày càng nghiêm trọng, hiệu quả điều trị cũng vì thế mà bị ảnh hưởng.
Theo thống kê có đến 80% trẻ mắc hội chứng mô bào có tổn thương xương, trong đó, phổ biến nhất ở xương sườn, xương hộp sọ, xương chậu, xương cánh tay, xương ổ mắt… Trẻ có thể phải đối mặt những cơn đau tại vị trí xương bị tổn thương kèm với biểu hiện sưng mô mềm từ đó dẫn đến các triệu chứng như viêm xương tai chũm tái diễn, viêm tai giữa, lồi mắt, gù vẹo cột sống…
Ngoài da, móng và xương, hội chứng mô bào còn có thể làm tổn thương một số cơ quan khác trong cơ thể như:
Để chẩn đoán hội chứng mô bào, bên cạnh các triệu chứng lâm sàng, các bác sĩ có thể chỉ định người bệnh làm thêm một số thăm dò cận lâm sàng để xác định chẩn đoán. Cụ thể:
Trong đó, xét nghiệm mô bệnh học được đánh giá là tiêu chuẩn vàng giúp chẩn đoán.

Nếu tình trạng chốc đầu ở trẻ xảy ra dai dẳng và điều trị da liễu không mang lại hiệu quả, các bậc cha mẹ không nên chủ quan mà thay vào đó, hãy đưa trẻ đến cơ sở y tế uy tín để được thăm khám để được tầm soát và phát hiện bệnh sớm. Việc phát hiện bệnh sớm và điều trị kịp thời có thể giúp ngăn ngừa các rủi ro đối với sức khỏe của trẻ.
Phác đồ điều trị hội chứng mô bào phụ thuộc vào các yếu tố như tình trạng, mức độ tổn thương và mức độ lan rộng. Việc điều trị sẽ dựa trên nguyên tắc sau:

Trên đây là toàn bộ những thông tin cơ bản xoay quanh hội chứng mô bào mà Nhà thuốc Long Châu đã tổng hợp để chia sẻ đến bạn đọc trong bài viết này. Có thể thấy rằng, hội chứng mô bào là căn bệnh ác tính, vô cùng nguy hiểm, gây ra rất nhiều triệu chứng giống với tình trạng chốc đầu thông thường mà trẻ hay gặp phải. Chính vì thế, hãy chủ động đưa trẻ đi khám nếu phát hiện dấu hiệu bất thường cha mẹ nhé. Điều này sẽ giúp phát hiện sớm bệnh và từ đó trẻ được điều trị kịp thời.
Xem thêm: Phân loại, triệu chứng của hội chứng lối thoát ngực (TOS)
:format(webp)/KF_1b_LIQ_Tx_J_Pb27_Vsh90_QN_6b_Xz_OB_Jo_U_f0e2294e2e.png)
Dược sĩ Đại họcNguyễn Chí Chương
Tốt nghiệp Đại Học Dược Hà Nội - chuyên môn Dược lâm sàng. Hiện đang là giảng viên cho Dược sĩ tại Nhà thuốc Long Châu.